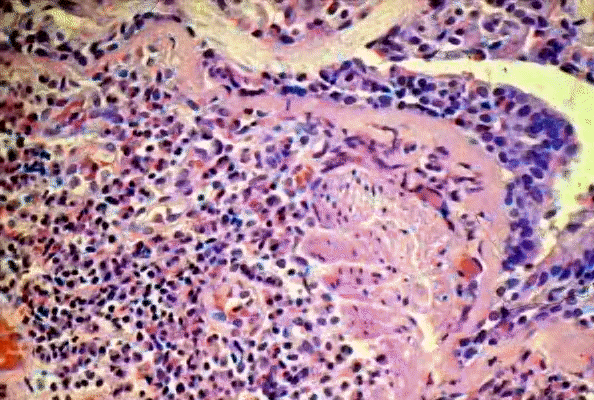

- "Bronchial asthma, higher power.
Notice inflammatory cells composed of lymphocytes
and many eosinophils. There is prominent
thickening of the basement membrane. "
- Ó
1999 KUMC Pathology and the University of Kansas,
used with permission; courtesy of Dr. James
Fishback, Department of Pathology, University of
Kansas Medical Center.
|